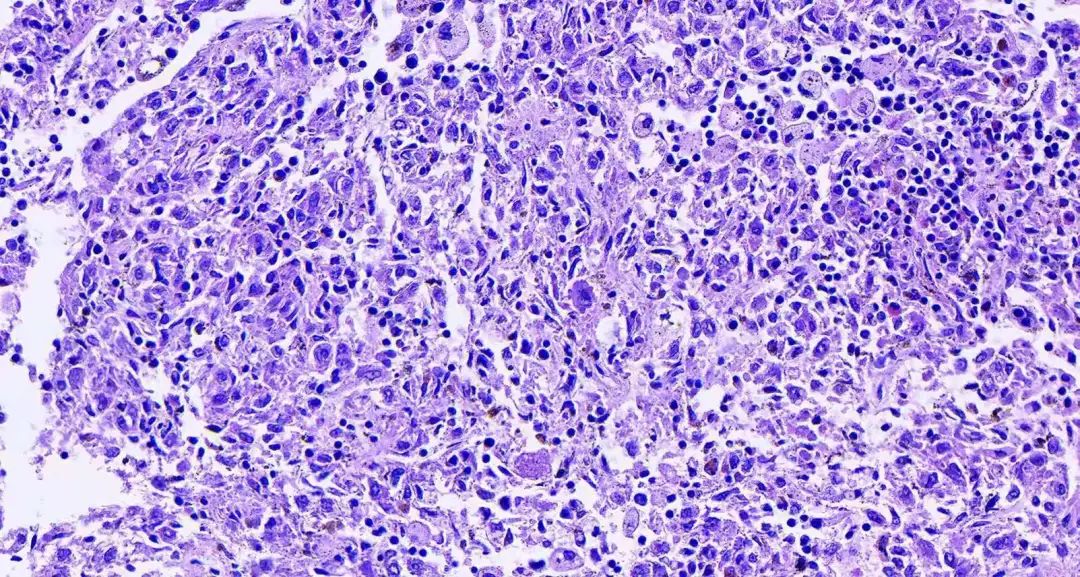
补硒可以软化肝硬化（肝硬化软化补硒可以长期吃吗）-硒宝网

补硒可以软化肝硬化(肝硬化软化补硒可以长期吃吗)
蓝润生物认为肝病患者病毒性肝炎、脂肪肝、肝硬化患者,血清硒浓度量显著比正常人低,因为当人摄入的硒含量不足时,肝脏中谷胱甘肽过氧化物酶的活性就会急剧下降,使得肝脏代谢活动中产生的有害过氧化物不能及时清除,致使肝脏出现种种病症。定量补硒,九硒可及时清除肝脏内的代谢产物,帮助肝脏分解毒素,提高自身免疫功能,使病情好转,而且又是防止肝脏癌变的有利措施之一。

蓝润生物认为癌症患者硒可以控制肿瘤细胞的生长分化,阻断癌细胞两条重要能量来源,癌细胞的一条能量来源是:癌细胞的氧酵解速度,是正常细胞的8倍,硒可以明显抑制这种酵解速度。癌组织另一个能量来源是氧化磷酸化过程,硒也能有效抑制它的发展。硒还能减轻化疗、放疗的毒副作用,在化疗中降低顺铂对肾、骨髓和肠道的毒性,是理想的顺铂解毒剂。总之,用硒来辅助防癌、治癌,可缓解癌症病人的疼痛,已成为科学界的新措施。

蓝润生物认为胃肠道患者慢性胃炎、消化道溃疡等疾病归根到底是消化道内的细菌、自由基等毒素在作祟。硒不但能够清除胃肠内的过氧化物、自由基、还能直接抑制肠道致病菌群,调节胃肠道内环境的平衡,修复和保护粘膜,是辅助治疗细胞免受自由基的损害,对烟民的生理损伤有修复作用,可帮助烟民较快戒烟,长期饮酒者,会使肝脏受损,表现为酒精性脂肪肝等,严重者可患肝硬化,定量补硒可加速酒精分解代谢,解除酒后不适,进而保护肝脏,便病症逐渐得到恢复。
蓝润生物认为青少年、营养不良经常感冒的儿童及渴望健康长寿的老人定量补硒可提高红细胞的携氧能力,使孩子的大脑得到充足的氧,在繁重的学习中不易疲劳、困倦、从而精力充沛。并能大大提高免疫力,促进生长,使青少年、儿童健康成长。随着年龄增长,人的新陈代谢逐步减慢,体内的废弃物也越来越多,定量补硒,可增加巨噬细胞吞噬能力及杀灭细菌的能力,把体内的废弃物及时排出体外,保持体内“绿色环境”。这样不仅可以延缓衰老,而且还能减少一般老人常有的抑郁、失眠、焦虑、疲劳等现象。据科学调查,白内障患者眼球部分的硒含量仅为正常人的六分之一,定量补硒,使眼中的水解酶达到最佳工作状态,改善眼部循环,排除毒素,从而达到改善白内障的目的。从根本上提高老年人的健康水平和生活质量。

继续阅读
- 暂无推荐
